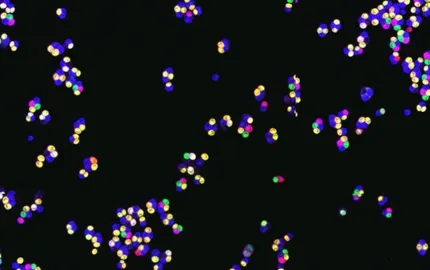

Présentation

Nous étudions la recombinaison et son importance pour la stabilité du génome et la ségrégation des chromosomes lors de la méiose, qui produit les gamètes haploïdes. La recombinaison a lieu lorsqu’un chromosome qui a subi une cassure utilise une séquence homologue pour sa réparation. Des défauts de la recombinaison ont des conséquences sévères, et sont liés à plusieurs maladies, comme certains cancers héréditaires et des syndromes d‘instabilité génétique.
La recombinaison peut être due à des lésions accidentelles, se produisant suite à l’exposition à des agents génotoxiques, ou lors d’accidents de la réplication, mais les lésions peuvent aussi être délibérément produites par la cellule, comme lors de la méiose. Lors de la méiose, un seul de chaque paire de chromosomes homologues parentaux est transmis à la descendence pour la reproduction sexuée. La recombinaison permet que des liens physiques, appelés crossing over, soient créés entre les chromosomes homologues, assurant ainsi leur bonne ségrégation à la première division méiotique. Les erreurs de recombinaison méiotique conduisent à la stérilité ou l’aneuploïdie et sont la cause majeure des anomalies chromosomiques telles que la trisomie 21.
La recombinaison est délenchée par la formation de cassures double brin le long deschromosomes, à des « poinds chauds » dont les déterminants sont mal connus (Fig. 1A). Seule une partie des cassures est réparée par un crossing over, ce qui implique une décision importante au moment de la réparation. Nous étudions les facteurs qui contrôlent la formation des cassures et des crossing over, et en particulier l’influence de la chromatine, de l’organisation chromosomique et nucléaire dans leur positionnement. La méiose est extrêmement bien conservée entre les espèces. Notre modèle d’étude est la levure S. cerevisiae, très proche en terme de mécanismes des mammifères et qui permet tout un éventail d’approches moléculaires, biochimiques et génétiques.
Les chromosomes méiotiques sont organisés en une succession de boucles ancrées à leur base à l’axe des chromosomes, où a lieu la recombinaison. Nous avons montré qu’une modification de la chromatine, la méthylation de l’histone H3K4, déposée par le complexe Set1, est importante pour la formation des cassures. En effet, une sous-unité du complexe Set1 se fixe directement à cette modification par un module spécifique, le PHD, et interagit avec les protéines formant les cassures sur l’axe des chromosomes, faisant le pont entre ces deux régions (Figure 1B). Ceci illustre l’importance de la chromatine pour la recombinaison méiotique.
Nous étudions également les mécanismes qui permettent de former un crossing over au cours de la réparation d’une cassure. Par l’étude génomique de Zip3, une protéine associée aux crossing over, nous avons mis en évidence une régulation de la formation des crossing over par les propriétés de la région chromosomique sous-jacente. Nous appliquons actuellement des approches protéomiques pour identifier les complexes protéiques impliqués dans la formation des crossing over.
Enfin, nous étudions comment la chromatine est modifiée suite à une cassure double-brin. Nous avons montré que deux chaperons d’histone, CAF-1 et Hir, s’associent spécifiquement aux cassures double-brin méiotiques, ce qui suggère l’incorporation de nouvelles histones dans la chromatine et potentiellement des modifications locales des propriétes de la chromatine.
Nos travaux devraient mener à une meilleure compréhension des mécanismes de transmission de l’information génétique au cours de la reproduction et de l’implication de la chromatine et de ses modifications dans la réparation des cassures par recombinaison, contribuant potentiellement à des changements épigénétiques à l’origine de pathologies.